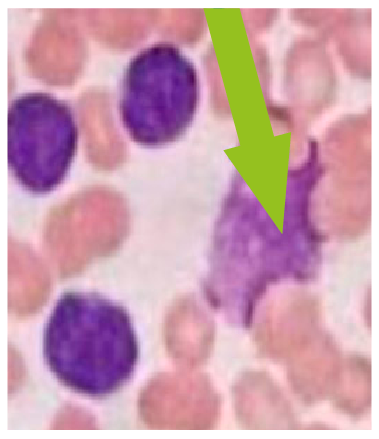

| ** | Latin American Journal of Clinical Sciences and Medical Technology is an open access magazine. To read all published articles and materials you just need to register Registration is free of charge. Register now If you already have registered please Log In | ** |
El diagnóstico de la leucemia linfocítica crónica (LLC) incrementa con la edad. Desconocemos su incidencia en México. Algunos factores de riesgo para desarrollar LLC son la predisposición familiar, la linfocitosis monoclonal, historia previa de cáncer y, probablemente, algunas infecciones. El diagnóstico se realiza con una historia clínica completa, exploración física y exámenes de laboratorio, entre ellos, estudios citogenéticos. La elección del tratamiento dependerá de la edad, estado funcional, comorbilidades, alteraciones citogenéticas, estadio clínico. En esta Oncoguía de leucemia linfocítica crónica se incluyen los criterios para iniciar tratamiento, así como los fármacos aprobados internacionalmente y en nuestro país. Asimismo, incluimos los criterios de respuesta al tratamiento y las recomendaciones de tratamiento de soporte.
The chronic lymphocytic leukemia (CLL) diagnosis increases with age. We do not know CLL incidence in Mexico. Some risk factors for developing CLL are the inherited predisposition, monoclonal lymphocytosis, history of cancer and, probably, some infections. The diagnosis is established with a complete medical history, physical examination, and laboratory tests, among them, cytogenetic ones. The treatment choice will depend on age, performance status, comorbidities, cytogenetic alterations, clinical stage. In Oncoguía de leucemia linfocítica crónica, we include the criteria to begin treatment, and the drugs approved internationally and in our country. Likewise, we comprise the response criteria to the treatment and the recommendations for the support treatment.
Estas guías son sugerencias y recomendaciones para el manejo de pacientes en condiciones ideales; no constituyen razonamientos costo-eficientes ni determinantes para la compra de medicamentos. El objetivo principal de esta Oncoguía de leucemia linfocítica crónica es contribuir a la homogeneidad de criterios en el manejo de dicha patología.
La leucemia linfocítica crónica (LLC) es una neoplasia de células B maduras, caracterizada por expansión clonal de linfocitos CD5 y CD23, funcionalmente incompetentes en la sangre, médula ósea y tejidos linfoides. Afecta principalmente a adultos mayores y tiene una presentación clínica y biológica heterogénea. Su cuenta de linfocitos es de >5 x 109/mcL en sangre periférica.1,2
Epidemiología
La LLC es la leucemia más frecuente en Europa y Estados Unidos; su incidencia es de 2-6 casos por 100 mil habitantes. Es más común en caucásicos que en negros americanos, rara en hispanos, nativos americanos y aún más rara en asiáticos.³
La incidencia en México se desconoce; sin embargo, hay tres estudios que reportan 6.6-9% de las leucemias diagnosticadas en adultos, de la cuales el 50% es población mestiza y el 50% restante caucásica. En 2017, un estudio registró 1,432 pacientes de instituciones del Valle de México, diagnosticados de 2007 a 2014, con media de edad al diagnóstico de 64.8 años. Hubo mayor incidencia en hombres que en mujeres.4,5
Factores de riesgo
Existe una predisposición familiar del 5-10% en pacientes con LLC. Ésta incrementa de 2 a 7 veces con el antecedente de la enfermedad en un familiar directo y suele presentarse en edades más tempranas. La linfocitosis monoclonal es otro factor de riesgo, ya que incrementa el riesgo de 1-2% al año.3,4,6 En una cohorte se observó que 16% de los pacientes tenía historia previa de cáncer y que el 11.2% desarrolló otra neoplasia durante el seguimiento (RR: 2.2).7 Otros autores demostraron relación con virus del herpes simple, hepatitis C y NAC (neumonía adquirida en la comunidad).8
El diagnóstico incrementa con la edad; la mediana es de 72 años y a la muerte de 79 años. Se inicia con la historia clínica, exploración física completa (incluidos hígado y bazo), desempeño físico del paciente y presencia o ausencia de síntomas B9 (Foto 1, Tablas 1 y 2).
| Tabla 1. Estudios diagnósticos obligatorios | |
|---|---|
| Estudios de laboratorio | Estudios citogenéticos FISH para t(11; 14), t(11q;v), rearreglos de inmunoglobulinas, ZAP70, del 17p/TP53 |
| Biometría con diferencial, química sanguínea, pruebas de función hepática con DHL | La clonalidad de las células B >5ml en sangre periférica debe ser confirmada por citometría: CD19, CD20, CD5, CD23, CD10, kappa/lambda, CD200 |
| Ácido úrico | Cariotipo |
| Beta 2 microglobulina | |
| Perfil viral (VIH, hepatitis B y C), serología para herpes 1 y 2, VZV, CMV y EBV | |
| Modificada de los autores NCCN, 2019.9 | |
| Tabla 2. Determinación de antígenos para diagnóstico | |||
|---|---|---|---|
| Antígeno | Expresión en leucemia linfocítica crónica (%) | Observaciones | |
Requeridos | CD19 CD5 CD23 CD20 IgK,IgL | Positivo >95 Positivo >20 Positivo >20 Débil Positivo y restringido | CD23 negativo sugiere linfoma del manto |
Recomendados | CD43 CD79b CD81 CD200 CD10 | Positivo >20 Débil Débil Positivo >20 Negativo <20 | CD200 habitualmente intensidad antagónica alta sugiere LLC o tricoleucemia; baja sugiere linfoma folicular, linfoma de células del manto |
| Modificada de Rawstrum AC, 2018; Gutiérrez C, 2019.10,11 | |||
En la Tabla 1 se observan los estudios a solicitar para realizar diagnóstico. En la Tabla 2 se enumeran los antígenos mínimos necesarios por citometría de flujo para realizar el diagnóstico. En la Tabla 3 se especifican los estudios a realizar en circunstancias especiales como anemia hemolítica, embarazo o presencia de múltiples adenopatías. El diagnóstico diferencial con linfoma de linfocitos pequeños requiere linfadenopatía y esplenomegalia con linfocitos < 5 mil en sangre periférica.9
| Tabla 3. Estudios a realizar en circunstancias especiales | |
|---|---|
| Cuantificación de inmunoglobulinas | Prueba de embarazo en edad reproductiva |
| Cuenta de reticulocitos, haptoglobina, Coombs directo | Biopsia aspirado de médula ósea |
| Tomografía axial computada simple y contrastada | Tomografía por emisión de positrones para biopsia guiada en sospecha de transformación |
| Biopsia del ganglio linfático Diagnóstico diferencial ciclina D1 para manto | Ecocardiograma / MUGA |
| Modificada de los autores NCCN, 2019.9 | |
Aspirado y biopsia de médula ósea
No es una indicación diagnóstica; sin embargo, ayuda con el pronóstico de acuerdo con el patrón de infiltración de los linfocitos. En las tablas 4 y 5 se observan las clasificaciones de Rai y Binet que son pronósticos para la LLC.
| Tabla 4. Estadificación clínica Rai | ||
|---|---|---|
| Estadio | Características clínicas | Media de supervivencia en años |
| 0 (bajo) | Linfocitosis en sangre periférica y médula ósea | > 10 |
| I y II riesgo intermedio | Linfadenopatías, esplenomegalia +/-, hepatomegalia | 7 |
| III y IV riesgo alto | Anemia, trombocitopenia | 0.75-4 |
| Modificada de NCCN, 2019.9 | ||
| Tabla 5. Estadificación clínica Binet | ||
|---|---|---|
| Estadio | Características clínicas | Media de supervivencia en años |
| A | Linfadenopatías en < 3 áreas, no anemia, no trombocitopenia | 12 |
| B | >3 áreas linfadenopatías, no anemia, no trombocitopenia | 7 |
| C | Hemoglobina <10, plaquetas<100 | 2-4 |
| Modificada de NCCN, 2019.9 | ||
La modificación de Lugano del sistema de estadificación de Ann Arbor se muestra en la Tabla 6.9 Se observa la clasificación clínica de acuerdo con los sitios de infiltración para poder determinar el estadio clínico del paciente.
| Tabla 6. Modificación de Lugano de estadificación clínica de Ann Arbor | ||
|---|---|---|
| Estadio | Involucro | Sitios extranodales |
| Estadio I Limitado | Un ganglio o grupo de ganglios adyacentes | Una lesión extranodal única, sin afección nodal |
| Estadio II | Dos o más grupos nodales en el mismo lado del diafragma | Estadio I o II con extensión nodal, con afección extranodal limitada a grupo contiguo |
| Estadio II Bulky | Estadio II, pero con enfermedad voluminosa | No aplica |
| Estadio III Avanzado | Ganglios en ambos lados del diafragma | No aplica |
| Ganglios por arriba del diafragma con afección esplénica | ||
| Estadio IV | Afección de tejido extralinfático no contiguo | No aplica |
| Modificada de NCCN, 2019.9 | ||
Auxiliares pronósticos
En la Tabla 7 se enumeran las alteraciones citogenéticas y mutaciones que nos ayudan a determinar el riesgo citogenético entre favorable o desfavorable.
| Tabla 7. Auxiliares pronósticos | ||
|---|---|---|
| Factores pronósticos y elección de tratamiento | Favorable | Desfavorable |
| FISH: t12; del (11q), del (13q), del (17p) Intermedio: cariotipo normal, +12 | Deleción 13q como alteración sola | Cualquier otra alteración del 17p |
| Secuenciación de TP53 | Silvestre | Mutado |
| Cariotipo complejo | > 3 alteraciones citogenéticas | |
| Análisis molecular para IGHV | >2% mutación | < 2% mutación |
Citometría de flujo | ||
| CD38 | < 30% | > 30% |
| Zap 70 | < 20% | > 20% |
| CD49d | < 30% | > 30% |
| Modificada de International CLL-IPI Working Group, 2016.12 | ||
Pronóstico12
Las tablas 8 y 9 se complementan en la determinación de los diferentes factores del paciente y del tumor para poder establecer un riesgo, y con éste, una supervivencia a 5 años.
| Tabla 8. Pronóstico | ||
|---|---|---|
| Criterio | Selección | Puntos |
| Edad | ≤65 años | 0 |
| >65 años | 1 | |
| Estadio clínico | Binet A o Rai 0 | 0 |
| Binet B-C o Rai I-IV | 1 | |
| B2 microglobulina (mg/L) | ≤3.5 | 0 |
| >3.5 | 2 | |
| Mutación IGHV | Mutada | 0 |
| No mutada | 2 | |
| Estado TP53 | Sin alteraciones | 0 |
| Deleción 17p (FISH) y/o mutación de TP53 | 4 | |
| Modificada de International CLL-IPI Working Group, 2016.12 | ||
| Tabla 9. Clasificación de riesgo | ||
|---|---|---|
| Puntaje | Riesgo | Supervivencia a 5 años |
| 0-1 | Riesgo bajo | 93.2% |
| 2-3 | Riesgo intermedio | 79.3% |
| 4-6 | Riesgo alto | 63.3% |
| 7-10 | Riesgo muy alto | 23.3% |
| Modificada de International CLL-IPI Working Group, 2016.12 | ||
Indicaciones de inicio de tratamiento12
La elección del tratamiento dependerá de la edad, estado funcional, comorbilidades, alteraciones citogenéticas, estadio clínico. En los pacientes no incluidos en grupos anteriores se podrá tomar la conducta de «observar y esperar». Existen criterios específicos para iniciar tratamiento en este tipo de neoplasia, ya que muchas veces su curso es indolente y no se observa mayor beneficio con el inicio temprano del tratamiento. Los criterios para inicio del tratamiento se mencionan en la Tabla 10.
| Tabla 10. Criterios para iniciar tratamiento en LLC (adaptada de iwCLL 2018) |
|---|
|
| Modificada de Hallek M, 2018; García Marco, 2013.13,14 |
Fármacos aprobados internacionalmente15
En la Tabla 11 se mencionan los medicamentos internacionalmente aprobados para el manejo de los pacientes con LLC.
| Tabla 11. Fármacos aprobados internacionalmente | |||
|---|---|---|---|
| Inhibidor de BTK (ibrutinib, acalabrutinib) | Inmunomoduladores (lenalidomida) | PI3K inhibidores (idelalisib, copanlisib y duvelisib) | Miméticos BH3 (venetoclax) |
| Modificadores epigenéticos EZH2 (tazemetostat) | Inmunoterapia CAR-T, CD19 | Anticuerpos monoclonales (rituximab y obinutuzumab) anti-CD20 | Anticuerpos conjugados con drogas contra CD79a (polatuzumab) |
| Anticuerpos Bi específicos (blinatumomab) | Quimioterapia: bendamustina, ciclofosfamida, doxorrubicina, vincristina, clorambucil, fludarabina, pentostatin | Esteroides: prednisona metilprednisolona | |
| Modificada de Jacobson CA, 2019.15 | |||
En la Tabla 12 se enlistan las recomendaciones de fármacos de acuerdo con la mutación presente por citogenética o secuenciación para el tratamiento de los pacientes con LLC.
| Tabla 12. Fármacos y tratamientos de acuerdo con el nivel de evidencia y recomendación | |
|---|---|
Menores de 65 años | |
| IGHV mutado, no del17/TP53 | |
|
|
| IGHV mutado, no del17p/TP53 | |
|
|
Mayores de 65 y no FIT | |
|
|
| Todos los demás, incluido el 17p/TP53 mutado | |
|
|
| Todos los demás, incluido el 17p/TP53 mutado | |
|
|
| *Categoría expresada de acuerdo con el nivel de evidencia y recomendación. Modificado de Alvarado M, 2019; NCCN, 2019; Woyach JA, 2019.4,6,16 | |
Criterios de respuesta a tratamiento
Para definir respuesta completa, todos los criterios deben cumplirse13:
| Tabla 13. Grupo internacional de LLC (iwCLL) | |||||
|---|---|---|---|---|---|
Parámetro | Respuesta completa (RC) | Respuesta parcial (RP) | Progresión de la enfermedad (PE) | Enfermedad estable (EE) | |
| A | Nódulos linfáticos | Ninguno ≥ 1.5 cm | Descenso ≥ 50% (del basal) | Incremento ≥ 50% (del basal o respuesta) | Cambio de - 49% a + 49% |
| Hígado y/o bazo | Bazo <13 cm; hígado normal | Descenso ≥ 50% (del basal) | Incremento ≥ 50% (del basal o respuesta) | Cambio de - 49% a + 49% | |
| Síntomas constitucionales | Ausentes | Cualquiera | Cualquiera | Cualquiera | |
| Linfocitos circulantes | Normal | Descenso ≥ 50% (del basal) | Incremento ≥ 50% (del basal o respuesta) | Cambio de - 49% a + 49% | |
| B | Plaquetas | ≥ 100 × 109/L | ≥ 100 × 109/L incremento de ≥ 50% del basal | Descenso de ≥ 50% del basal por LLC | Cambio de - 49% a + 49% |
| Hemoglobina | ≥ 11.0 g/dL | ≥ 11.0 g/dL o incremento de 50% del basal | Descenso de ≥ 2 g/dL del basal por LLC | Incremento <11-0 g/dL o < 50% del basal o descenso < 2 g/dL | |
| Médula ósea | Normocelular sin células LLC ni nódulos de linfocitos B | Presencia de células de LLC o nódulos de linfocitos B | Incremento de células de LLC 50% en biopsias sucesivas | Sin cambios en infiltrados de médula ósea | |
| El grupo A mide carga tumoral; el grupo B mide el estado de médula ósea. Modificada de Hallek M, 2018.13 | |||||

Categorías de LLC (recaída/refractaria)
Actualmente, la LLC de riesgo alto (Figura 1) se divide en:
Categoría I (quimio-inmunoterapia resistente, QT-I). Pacientes con anomalía de TP53, con falla a QT-I, pero que responden a inhibidores de tirosincinasa /BCL2i.
Categoría II (QT-I resistente y resistente a inhibidor de vía, IP). Incluye a los pacientes con o sin mutación de TP53, que no respondieron a ninguna de las dos terapias, incluso si responden a IP alterno (BTKi).17
Terapia de soporte
Existen recomendaciones para prevención de infecciones (Tabla 14).18-22 La profilaxis para el síndrome de lisis tumoral consiste en seguimiento de electrolitos séricos (sodio, potasio, ácido úrico, fósforos, calcio y deshidrogenasa láctica).
| Tabla 14. Recomendaciones para prevención de eventos infecciosos | ||
|---|---|---|
| Profilaxis | Recomendación | Especificaciones |
Antifúngica | Trimetroprim-sulfametoxazol 800/160 mg al día durante el período de neutropenia. Fluconazol 100 mg al día durante el período de neutropenia. | En esquemas de quimioterapia con >3.5% de riesgo de presentar neumonía por PCP: dosis de esteroide equivalente a 20 mg/día de prednisona por más de 1 mes y/o análogos de purina. Pacientes en los que se espera neutropenia profunda y prolongada y/o con mucositis grado 3 ó 4 que les condiciona alto riesgo de candidemia. |
Antiviral | Aciclovir oral 400 mg cada 12 h o valaciclovir oral 500 mg c/12 h durante el período de neutropenia. Inhibidores de transcriptasa reversa de análogos de nucleósidos (entecavir o tenofovir). Tomar en cuenta que este grupo de pacientes tiene riesgo de presentar reactivación de CMV. | En pacientes con serología positiva para herpes simple. En pacientes con alto riesgo de reactivación (infección crónica por hepatitis B). Sospecha clínica en presencia de alteraciones oculares, neumonitis y/o úlceras en tubo digestivo. En ese caso se debe realizar medición de carga viral de CMV o antígeno PP65. Evidencia histopatológica de inclusiones citomegálicas, es suficiente para inicio del tratamiento. |
Antibacteriana | Profilaxis antimicrobiana con quinolonas en pacientes con neutropenia no se recomienda en nuestro contexto clínico y epidemiológico. | En México, la resistencia a este antimicrobiano es mayor al 65% y no brindaría adecuada cobertura para BGN. También se ha demostrado que el uso de quinolonas aumenta el riesgo de infección por enterococos resistentes a vancomicina y de colitis por C. difficile. |
Inmunizaciones | Aplicación anual de vacuna contra influenza acelular y, en su ausencia, virus inactivos. Vacuna neumocócica conjugada de 13 serotipos seguida de vacuna polisacárida 23 valente con 8 semanas de diferencia y aplicar cada 5 años. Vacunación contra virus de hepatitis B en pacientes seronegativos. | Prohibido el uso de cualquier vacuna que contenga virus vivos. Seguir recomendaciones de vacunación para el paciente inmunosuprimido de la Sociedad Americana de Infectología (IDSA). |
Adicionales | Prevención de infecciones en el hospital y en el contexto ambulatorio. | Apegarse a las medidas de higiene de manos y etiqueta respiratoria. Pacientes ambulatorios deben evitar la exposición prolongada a zonas con alta carga de esporas (zonas de construcción, excavación, demolición y no realizar actividades como jardinería, cavar o sembrar). |
| PCP: Pneumocystis jiroveccii; CMV: citomegalovirus; BGN: bacterias gramnegativas. Rubin LG, 2014; Garza-Montúfar ME, 2018; -Garza-González E, 2019; Bow EJ, 2011; Taplitz R, 2018.18-22 | ||
El tratamiento se basa en hidratación vigorosa oral: 1.5-2 l/24h, intravenosa 2L, alopurinol, febuxostat, rasburicasa (Tabla 15).9 Tromboprofilaxis para el grupo que recibe lenalidomida con aspirina 81-100 mg via oral c/24h.
| Tabla 15. Profilaxis para lisis tumoral | ||
|---|---|---|
| Carga tumoral | Profilaxis | Estudios de laboratorio |
| Bajo Ganglios <5 cm o Linfocitos totales < 25 × 109/L | Hidratación oral (1.5-2 L) Alopurinol | Externos Pre dosis, 6-8 h, 24 h primera dosis de inicio de tratamiento |
| Medio Ganglios > 5 cm-< 10 cm o Linfocitosis totales ≥ 25 × 109/L | Hidratación oral (1.5-2 L) y considerar hidratación intravenosa adicional Alopurinol | Externos Pre dosis, 6-8 h, 24 h primera dosis de inicio de tratamiento Considerar hospitalización para pacientes con depuración de creatinina <80 ml/min |
| Alto Ganglios > 10 cm o Linfocitos totales > 25 × 109/L y ganglio ≥ 5 cm | Hidratación oral (1.5-2 L) y considerar hidratación intravenosa adicional Alopurinol o febuxostat Considerar rasburicasa si el ácido úrico basal está elevado | Hospitalizados Pre dosis, 4,8,12 y 24 h primera dosis de inicio de tratamiento |
| Modificada de NCCN, 2019.9 | ||
Estas guías conjuntan tanto la evidencia publicada como la experiencia de nuestra institución. Se debe hacer un mayor esfuerzo por determinar la epidemiología en nuestro país, no sólo de LLC, sino de todas las neoplasias hematológicas. También se debe resaltar la importancia de los tratamientos de soporte.
Los autores declaran no tener conflicto de interés.
| 1. | Baliakas P, Jeromin S, Iskas M, Puiggros A, Plevova K, Nguyen-Khac F, et al. Cytogenetic complexity in chronic lymphocytic leukemia: Definitions, associations, and clinical impact. Blood. 2019;133(11):1205-16. |
| 2. | Alvarado-Ibarra M, Mena-Zepeda V, Nava-Villegas L, Estrada-Domínguez P, Alcivar-Cedeño LM, Martínez-Ríos A, et al. Guía de tratamiento de la leucemia linfocítica crónica/linfoma de linfocitos pequeños. Rev Hematol Mex. 2019;20(3):210-223. |
| 3. | Gribben JG. How I treat CLL up front. Blood. 2010;115(2):187-197. |
| 4. | Alvarado-Ibarra M, Mena-Zepeda V, Nava-Villegas L, Estrada-Domínguez P, Alcivar-Cedeño LM, Martínez-Ríos A, et al. Chronic lymphocytic leukaemia/ small lymphocytic lymphoma treatment guidelines. Cancer Therapy and Oncology International Journal. United States: Juniper Publishers, 2019. |
| 5. | Santoyo-Sánchez A, Ramos-Peñafiel CO, Saavedra-González A, González-Almanza L, Martínez-Tovar A, Olarte-Carrillo I, et al. Frecuencia de edad y género de pacientes con leucemia en dos centros de referencia del Valle de México. Gac Med Mex. 2017;153(1):44-48. |
| 6. | Labardini Méndez JR, Cervera Ceballos E, Corrales Alfaro C, Balbuena Martínez M, Barbosa Ibarra AA, Espinoza Zamora JR, et al. Onco Guía de Leucemia Linfocítia crónica.Cancerología. 2010;117-120. |
| 7. | Tsimberidou AM, Wen S, McLaughlin P, O´Brien S, Wierda WG, Lerner S, et al. Other malignancies in chronic lymphocytic leukemia/small lymphocytic lymphoma. J Clin Oncol. 2009;27(6):904-10. |
| 8. | Anderson LA, Landgren O, Eagles EA. Common community acquired infections and subsequent risk of chronic lymphocytic leukemia. Br J Haematol. 2009;147(4):444-9. |
| 9. | National Comprehensive Cancer Network. Wierda WG, Byrd JC, Abramson JS, Bilgrami SF, Bociek G, Brander D, et al.Chronic lymphocytic leukemia/small lymphocytic lymphoma. Version 4.2020, NCCN Clinical Practice Guidelines in Oncology. Available from URL: https://jnccn.org/view/journals/jnccn/18/2/article-p185.xml |
| 10. | Rawstrum AC, Kreuzer KA, Soosapilla A, Spacek M, Stehlikova O, Gambell P, et al. Reproducible diagnosis of chronic lymphocityc leukemia by flow cytometry: An European research initiative on CLL (ERIC) & European Society for Clinical Cell Analysis (ESCCA) harmonisation project. Citometry B Clin Cytom. 2018;94(1):121-28. |
| 11. | Gutiérrez C, Wu CJ. Clonal dynamics in chronic lymphocytic leukemia. Hematology Am Soc Hematol Educ Program. 2019;2019(1):466-75. |
| 12. | International CLL-IPI working group. An international prognostic index for patients with chronic lymphocytic leukaemia (CLL-IPI): A meta-analysis of individual patient data. Lancet Oncol. 2016;17(6):779–90. |
| 13. | Hallek M, Cheson BD, Catovsky D, Caligaris-Cappio F, Dighiero G, Hillmen P, et al. iwCLL guidelines for diagnosis, indications for treatment, response assessment,and supportive management of CLL [Internet]. 2018 Available from URL: https://ashpublications.org/blood/article/131/25/2745/37141/iwCLL-guidelines-for-diagnosis-indications-for |
| 14. | García Marco JA, Giraldo Castellano P, López Jiménez J, Ríos Herranz E, Sastre Moral JL, Terol Casterá MJ, et al. Guía de consenso nacionales para el estudio y tratamiento de los pacientes con leucemia linfocítica crónica. Med Clin. 2013;141(4):175-175. |
| 15. | Jacobson CA. Indolent lymphomas: Pushing the pace with novel agents. Hematology Am Soc Hematol Educ Program. 2019;2019(1):279-286. |
| 16. | Woyach JA. Treatment-naive CLL: Lessons from phase 2 and phase 3 clinical trials. Blood. 2019; 134(21):1796-1801. |
| 17. | Dreger P, Ghia P, Schetelig J, van Gelder M, Kimby E, Michallet M, et al. High-risk chronic lymphocytic leukemia in the era of pathway inhibitors: Integrating molecular and cellular therapies. Blood. 2018;132(9):892-902. |
| 18. | Rubin LG, Levin MJ, Ljungman P, Graham Davies E, Avery R, Tomblyn M, et al. 2013 IDSA clinical practice guideline for vaccination of the immunocompromised host. Clin Infect Dis. 2014;58(3):e44-100. |
| 19. | Garza-Montúfar ME, Treviño-Valdez PD, De la Garza-Salinas LH. Comorbidities and antimicrobial resistance in urological outpatients with positive urine culture. Rev Med Inst Mex Seguro Soc. 2018;56(4):347-53. |
| 20. | Garza-González E, Morfín-Otero R, Mendoza-Olazarán S, Bocanegra-Ibarias P, Flores-Treviño S. Rodríguez-Noriega E, et al. A snapshot of antimicrobial resistance in Mexico. Results from 47 centers from 20 states during a six-month period. PLoS One. 2019;14(3):e0209865. |
| 21. | Bow EJ. Fluoroquinolones, antimicrobial resistance and neutropenic cancer patients. Curr Opin Infect Dis. 2011;24(6):545-53. |
| 22. | Taplitz RA, Kennedy EB, Bow EJ, Crews J, Gleason C, Hawley DK, et al. Antimicrobial prophylaxis for adult patients with cancer- related immunosuppression: ASCO and IDSA Clinical Practice Guideline update. J Clin Oncol. 2018;36(30):3043-54. |